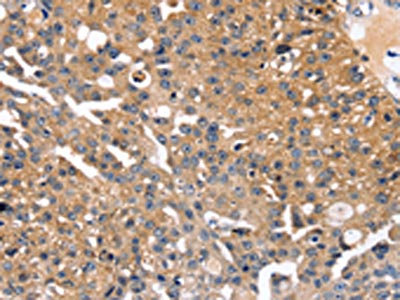

SLC2A2 Antibody
-
中文名稱:SLC2A2兔多克隆抗體
-
貨號:CSB-PA054783
-
規(guī)格:¥1100
-
圖片:
-
The image on the left is immunohistochemistry of paraffin-embedded Human breast cancer tissue using CSB-PA054783(SLC2A2 Antibody) at dilution 1/35, on the right is treated with synthetic peptide. (Original magnification: ×200)
-
The image on the left is immunohistochemistry of paraffin-embedded Human esophagus cancer tissue using CSB-PA054783(SLC2A2 Antibody) at dilution 1/35, on the right is treated with synthetic peptide. (Original magnification: ×200)
-
-
其他:
產(chǎn)品詳情
-
Uniprot No.:
-
基因名:
-
別名:liver antibody; Glucose Transporter 2 antibody; Glucose Transporter GLUT2 antibody; Glucose transporter type 2 antibody; Glucose transporter type 2 liver antibody; Glucose transporter, liver/islet antibody; GLUT-2 antibody; GLUT2 antibody; GTR2_HUMAN antibody; GTT2 antibody; SLC2A2 antibody; Solute carrier family 2 (facilitated glucose transporter) member 2 antibody; Solute carrier family 2 facilitated glucose transporter member 2 antibody; Solute carrier family 2, facilitated glucose transporter member 2 antibody
-
宿主:Rabbit
-
反應(yīng)種屬:Human
-
免疫原:Synthetic peptide of Human SLC2A2
-
免疫原種屬:Homo sapiens (Human)
-
標(biāo)記方式:Non-conjugated
-
抗體亞型:IgG
-
純化方式:Antigen affinity purification
-
濃度:It differs from different batches. Please contact us to confirm it.
-
保存緩沖液:-20°C, pH7.4 PBS, 0.05% NaN3, 40% Glycerol
-
產(chǎn)品提供形式:Liquid
-
應(yīng)用范圍:ELISA,IHC
-
推薦稀釋比:
Application Recommended Dilution ELISA 1:2000-1:5000 IHC 1:25-1:100 -
Protocols:
-
儲存條件:Upon receipt, store at -20°C or -80°C. Avoid repeated freeze.
-
貨期:Basically, we can dispatch the products out in 1-3 working days after receiving your orders. Delivery time maybe differs from different purchasing way or location, please kindly consult your local distributors for specific delivery time.
-
用途:For Research Use Only. Not for use in diagnostic or therapeutic procedures.
引用文獻(xiàn)
相關(guān)產(chǎn)品
靶點(diǎn)詳情
-
功能:Facilitative hexose transporter that mediates the transport of glucose and fructose. Likely mediates the bidirectional transfer of glucose across the plasma membrane of hepatocytes and is responsible for uptake of glucose by the beta cells; may comprise part of the glucose-sensing mechanism of the beta cell. May also participate with the Na(+)/glucose cotransporter in the transcellular transport of glucose in the small intestine and kidney. Also able to mediate the transport of dehydroascorbate.
-
基因功能參考文獻(xiàn):
- Data suggest that the following genetic modifications are involved in neonatal diabetes mellitus patients in Oman: (1) mutation in KCNJ11 (potassium voltage-gated channel subfamily J member 11; one patient); (2) mutation in GCK (glucokinase); (3) mutation in SLC2A2 (glucose transporter type 2); (4) chromosome 6q24 methylation abnormalities. PMID: 29329106
- Results showed the glucose transporter GLUT2 was highly expressed in the lumen of sweat glands from atopic dermatitis (AD) patients. AD patients with chronic inflammation had significantly increased GLUT2 mRNA expression and near normal sweat glucose levels. PMID: 29677207
- Data suggest expression of SGLT1 is markedly increased in kidney of patients with type 2 diabetes as compared to control subjects; SGLT1 mRNA is highly and significantly correlated with fasting and postprandial plasma glucose and HbA1c. In contrast, data suggest SGLT2 and GLUT2 mRNA in kidney are down-regulated in type 2 diabetes, but not to statistically significant level. (SGLT = sodium-glucose co-transporter) PMID: 28477418
- The mutant tumors exhibited impaired proliferation, anoikis resistance, and migratory capability and had reduced adenylate energy charge. Further investigations also revealed that cANGPTL4 regulated the expression of Glut2 PMID: 28641978
- Single nucleotide polymorphism in SLC2A2 gene is associated with glycemic response to metformin in Type 2 diabetes. PMID: 27500523
- no significant associations between GLUT2 and/or TAS1R2 polymorphisms and fillings were found, but allele frequencies of the TAS1R2 variant were marginally significantly different between children with DMFT = 0 and DMFT >/=1. no significant interaction between both genes and risk of dental caries was found. GLUT2 and TASR1 polymorphisms may influence the risk of caries in the Czech population PMID: 26112465
- Three novel variants and seven single-nucleotide polymorphisms associated with the myelomeningocele phenotype. PMID: 25776730
- Homozygous splice-site mutation IVS8+5G>C (c.1068+5 G>C) of SLC2A2 was found in patient A and homozygous nonsense mutation c.1194T>A (p.Tyr398X) in patient B. Patient C harboured a missense mutation c.380C>A (p.Ala127Asp) PMID: 25919556
- Data identified the last enzyme of the de novo purine synthesis pathway 5-aminoimidazole-4-carboxamide ribonucleotide formyltransferase/IMP cyclohydrolase (ATIC)and the putative tyrosine phosphatase PTPLAD1 as new regulators of Glut2(SLC2A2)translocation in HEK293 cells. SiRNA-mediated knockdown of ATIC delayed insulin response of Glut2 translocation while depletion of PTPLAD1(HACD3} strongly enhanced it in HEK293 cells. PMID: 25687571
- A novel 6 nucleotide deletion in GLUT2 gene, a member of the facilitative glucose transporter family, is shown to be segregated with Fanconi-Bickel syndrome in an Iranian family. PMID: 25523092
- SGLT1 or GLUT2 interact with the cytoskeleton in the intestinal epithelium during hexose absorption. PMID: 25711084
- Mutations in the GLUT2 gene is associated with ccute metabolic acidosis in Fanconi-Bickel syndrome. PMID: 25165176
- GLUT-2 expression may be associated with cholangiocarcinogenesis of large bile duct and is a helpful marker for detecting high-grade biliary intraepithelial neoplasia lesions in atypical bile ducts. PMID: 24824030
- SGLT1 mRNA and GLUT2 mRNA expression are reduced significantly in CACo-2 cells exposed to berry extracts. PMID: 24236070
- the first gain of function mutations for hGLUT2, revealing the importance of its receptor versus transporter function in pancreatic beta cell development and insulin secretion. PMID: 23986439
- associated with caries risk PMID: 23257979
- This study determined if single nucleotide polymorphisms in genes involved in fructose transport,SLC2A2 and SLC2A5 and metabolism, etohexokinase affect inter-individual variability in metabolic phenotypes. PMID: 23341889
- Intestinal dehydroascorbic acid (DHA) transport is mediated by the facilitative sugar transporters, GLUT2 and GLUT8 PMID: 23396969
- Genetic variant SLC2A2 is marginally associated with risk of cardiovascular disease in type 2 diabetes mellitus patients. PMID: 23185617
- Mutation analysis of the GLUT2 gene in three unrelated Egyptian families with Fanconi-Bickel syndrome detected three different mutations. PMID: 22350464
- Case-control analyses revealed a unique association between the G allele of rs9875793 and bipolar disorder patients with 'negative mood delusions' compared with controls. PMID: 23010768
- GLUT2 gene expression is suppressed in Hepatitis C virus infection via downregulation of HNF-1alpha expression at transcriptional and posttranslational levels. PMID: 22993150
- The finding that patients with homozygous SLC2A2 mutations can have neonatal diabetes supports a role for GLUT2 in the human beta cell. PMID: 22660720
- Homozygous mutations in GLUT2, which cause Fanconi-Bickel syndrome, can lead to very different clinical and biochemical findings that are not limited to mild proximal renal tubulopathy but can include significant hypercalciuria. PMID: 22865906
- report on two siblings with Fanconi-Bickel syndrome (FBS) and an unusually mild clinical course; both patients were found to be compound heterozygous for the novel GLUT2 (SLC2A2) mutations c.457_462delCTTATA (p.153_4delLI) and c.1250C>G (p.P417R) PMID: 22214819
- Constitutive expression of GLUT2 in the apical membrane along with additional translocation of cytoplasmic GLUT2 to the apical membrane via an intact cytoskeleton and activated PKC appears responsible for enhanced carrier-mediated glucose uptake. PMID: 21943636
- We report the first Chinese cases of Fanconi-Bickel syndrome (FBS),a rare inherited disease caused by mutations in the glucose transporter 2 gene, SLC2A2. PMID: 22145468
- In human enterocytes, GLUT2 was consistently located in basolateral membranes; mice on a low-carbohydrate/high-fat diet for 12 months also exhibited endosomal GLUT2 accumulation and reduced glucose absorption. PMID: 21852673
- Polyphenols, phenolic acids and tannins from strawberry and apple are potent inhibitors of GLUT2 and SGLT1 at concentrations predicted after dietary ingestion. PMID: 20564476
- prostate cancer was inversely associated with the SLC2A2 rs5400 Thr110 allele PMID: 20142250
- Intestinal glucose absorption by the apical GLUT2 pathway can be 3 to 5-times greater then by SGLT1 et the high concentration of sugar. PMID: 20201351
- Genetic polymorphisms of SLC2A2 and HP is associated with serum cholesterol levels. PMID: 20066028
- mutated in patients with fanconi-Bickel syndrome PMID: 11810292
- Hepatocyte nuclear factor-1alpha recruits the transcriptional co-activator p300 on the GLUT2 gene promoter. PMID: 11978637
- polymorphisms at positions -269, -44, or + 103 may affect GLUT2 gene transcription, possibly associated with reduced expression of the GLUT2 gene in NIDDM patients. PMID: 12017192
- Expression is responsible for resistance to alloxan and streptozotocin toxicity. PMID: 14614558
- We have found GLUT-2 and glucokinase mRNAs in several brain regions, including the ventromedial and arcuate nuclei of the hypothalamus PMID: 15009676
- SNPs of SLC2A2 predict the conversion to diabetes in obese subjects with impaired glucose tolerance. PMID: 15983230
- identify Glut2 as a GroPIns transporter in mammals, and define a physiologically relevant cell-permeation mechanism PMID: 17141226
- kidney of diabetic rats, an initial and transient upregulation of GLUT2 was induced specifically by insulin only. PMID: 17204838
- recent progress in elucidating the transcriptional regulation of GLUT2 in the liver and pancreatic beta-cells and the relevance to type 2 diabetes.[RREVIEW] PMID: 18220613
- Data show that glucose transport in human airway epithelial cells in vitro and in vivo utilises GLUT2 transporters, and suggest that these transporters could contribute to glucose uptake/homeostasis in the human airway. PMID: 18239936
- Our findings show that a genetic variation in GLUT2 is associated with habitual consumption of sugars, suggesting an underlying glucose-sensing mechanism that regulates food intake. PMID: 18349384
- The contribution of GLUT2 to human metabolic diseases (Review) PMID: 19223655
- combined presence of rs5393 & rs5394 polymorphisms of GLUT2 was more frequent in type 2 diabetics than non-diabeteics; rs5394 appeared to be associated with decreased glucose stimulated insulin release & a tendency to a reduced GLUT2 gene expression PMID: 19269875
- The expression pattern of GLUT2 is reported in newly diagnosed esophageal adenocarcinoma by means of immunohistochemistry. PMID: 19554504
顯示更多
收起更多
-
相關(guān)疾病:Fanconi-Bickel syndrome (FBS)
-
亞細(xì)胞定位:Cell membrane; Multi-pass membrane protein.
-
蛋白家族:Major facilitator superfamily, Sugar transporter (TC 2.A.1.1) family, Glucose transporter subfamily
-
組織特異性:Liver, insulin-producing beta cell, small intestine and kidney.
-
數(shù)據(jù)庫鏈接:
Most popular with customers
-
-
YWHAB Recombinant Monoclonal Antibody
Applications: ELISA, WB, IHC, IF, FC
Species Reactivity: Human, Mouse, Rat
-
Phospho-YAP1 (S127) Recombinant Monoclonal Antibody
Applications: ELISA, WB, IHC
Species Reactivity: Human
-
-
-
-
-